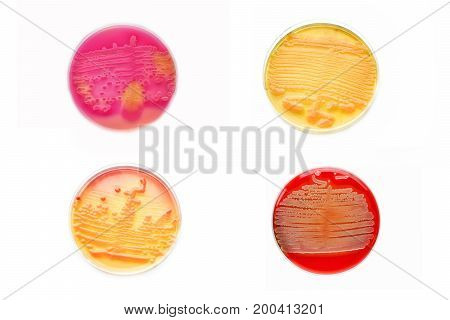
Mixed of bacteria colonies in various petri dish

Ušetřete s předplatným Bigstock. Více informací >
zavřít
snímek
snímky
diplococcus
fotografie z fotobanky
(Celkový počet výsledků: 207)